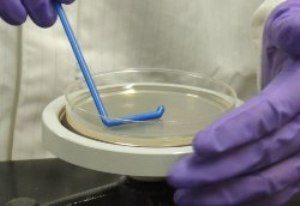
global-food-microbiology-and-safety-equipment-market

2016 Global Food Microbiology and Safety Equipment Industry Report is a professional and in-depth research report on the world’s major regional market conditions of the Food Microbiology and Safety Equipment industry, focusing on the main regions (North America, Europe and Asia) and the main countries (United States, Germany, Japan and China).
2016 Global Food Microbiology and Safety Equipment Industry Report is a professional and in-depth research report on the world’s major regional market conditions of the Food Microbiology and Safety Equipment industry, focusing on the main regions (North America, Europe and Asia) and the main countries (United States, Germany, Japan and China).
Browse Full Report With TOC @ http://www.fiormarkets.com/report/global-food-microbiology-and-safety-equipment-market-research-6105.html
The report firstly introduced the Food Microbiology and Safety Equipment basics: definitions, classifications, applications and industry chain overview; industry policies and plans; product specifications; manufacturing processes; cost structures and so on. Then it analyzed the world’s main region market conditions, including the product price, profit, capacity, production, capacity utilization, supply, demand and industry growth rate etc. In the end, the report introduced new project SWOT analysis, investment feasibility analysis, and investment return analysis.
The report includes six parts, dealing with: 1.) basic information; 2.) the Asia Food Microbiology and Safety Equipment industry; 3.) the North American Food Microbiology and Safety Equipment industry; 4.) the European Food Microbiology and Safety Equipment industry; 5.) market entry and investment feasibility; and 6.) the report conclusion.
Request For Sample Report @ http://www.fiormarkets.com/report-detail/6105/request-sample
Table of Contents
Part I Food Microbiology and Safety Equipment Industry Overview
Chapter One Food Microbiology and Safety Equipment Industry Overview
1.1 Food Microbiology and Safety Equipment Definition
1.2 Food Microbiology and Safety Equipment Classification Analysis
1.2.1 Food Microbiology and Safety Equipment Main Classification Analysis
1.2.2 Food Microbiology and Safety Equipment Main Classification Share Analysis
1.3 Food Microbiology and Safety Equipment Application Analysis
1.3.1 Food Microbiology and Safety Equipment Main Application Analysis
1.3.2 Food Microbiology and Safety Equipment Main Application Share Analysis
1.4 Food Microbiology and Safety Equipment Industry Chain Structure Analysis
1.5 Food Microbiology and Safety Equipment Industry Development Overview
1.5.1 Food Microbiology and Safety Equipment Product History Development Overview
1.5.1 Food Microbiology and Safety Equipment Product Market Development Overview
1.6 Food Microbiology and Safety Equipment Global Market Comparison Analysis
1.6.1 Food Microbiology and Safety Equipment Global Import Market Analysis
1.6.2 Food Microbiology and Safety Equipment Global Export Market Analysis
1.6.3 Food Microbiology and Safety Equipment Global Main Region Market Analysis
1.6.4 Food Microbiology and Safety Equipment Global Market Comparison Analysis
1.6.5 Food Microbiology and Safety Equipment Global Market Development Trend Analysis
Chapter Two Food Microbiology and Safety Equipment Up and Down Stream Industry Analysis
2.1 Upstream Raw Materials Analysis
2.1.1 Upstream Raw Materials Price Analysis
2.1.2 Upstream Raw Materials Market Analysis
2.1.3 Upstream Raw Materials Market Trend
2.2 Down Stream Market Analysis
2.1.1 Down Stream Market Analysis
2.2.2 Down Stream Demand Analysis
2.2.3 Down Stream Market Trend Analysis
Part II Asia Food Microbiology and Safety Equipment Industry (The Report Company Including the Below Listed But Not All)
Chapter Three Asia Food Microbiology and Safety Equipment Market Analysis
3.1 Asia Food Microbiology and Safety Equipment Product Development History
3.2 Asia Food Microbiology and Safety Equipment Process Development History
3.3 Asia Food Microbiology and Safety Equipment Industry Policy and Plan Analysis
3.4 Asia Food Microbiology and Safety Equipment Competitive Landscape Analysis
3.5 Asia Food Microbiology and Safety Equipment Market Development Trend
Chapter Four 2011-2016 Asia Food Microbiology and Safety Equipment Productions Supply Sales Demand Market Status and Forecast
4.1 2011-2016 Food Microbiology and Safety Equipment Capacity Production Overview
4.2 2011-2016 Food Microbiology and Safety Equipment Production Market Share Analysis
4.3 2011-2016 Food Microbiology and Safety Equipment Demand Overview
4.4 2011-2016 Food Microbiology and Safety Equipment Supply Demand and Shortage
4.5 2011-2016 Food Microbiology and Safety Equipment Import Export Consumption
4.6 2011-2016 Food Microbiology and Safety Equipment Cost Price Production Value Gross Margin
Chapter Five Asia Food Microbiology and Safety Equipment Key Manufacturers Analysis
5.1 Company A
5.1.1 Company Profile
5.1.2 Product Picture and Specification
5.1.3 Product Application Analysis
5.1.4 Capacity Production Price Cost Production Value
5.1.5 Contact Information
5.2 Company B
5.2.1 Company Profile
5.2.2 Product Picture and Specification
5.2.3 Product Application Analysis
5.2.4 Capacity Production Price Cost Production Value
5.2.5 Contact Information
5.3 Company C
5.3.1 Company Profile
5.3.2 Product Picture and Specification
5.3.3 Product Application Analysis
5.3.4 Capacity Production Price Cost Production Value
5.3.5 Contact Information
5.4 Company D
5.4.1 Company Profile
5.4.2 Product Picture and Specification
5.4.3 Product Application Analysis
5.4.4 Capacity Production Price Cost Production Value
5.4.5 Contact Information
Contact Us
Mark Stone
Sales Manager
Phone: (201) 465-4211
Email: sales@fiormarkets.com
Web: www.fiormarkets.com
